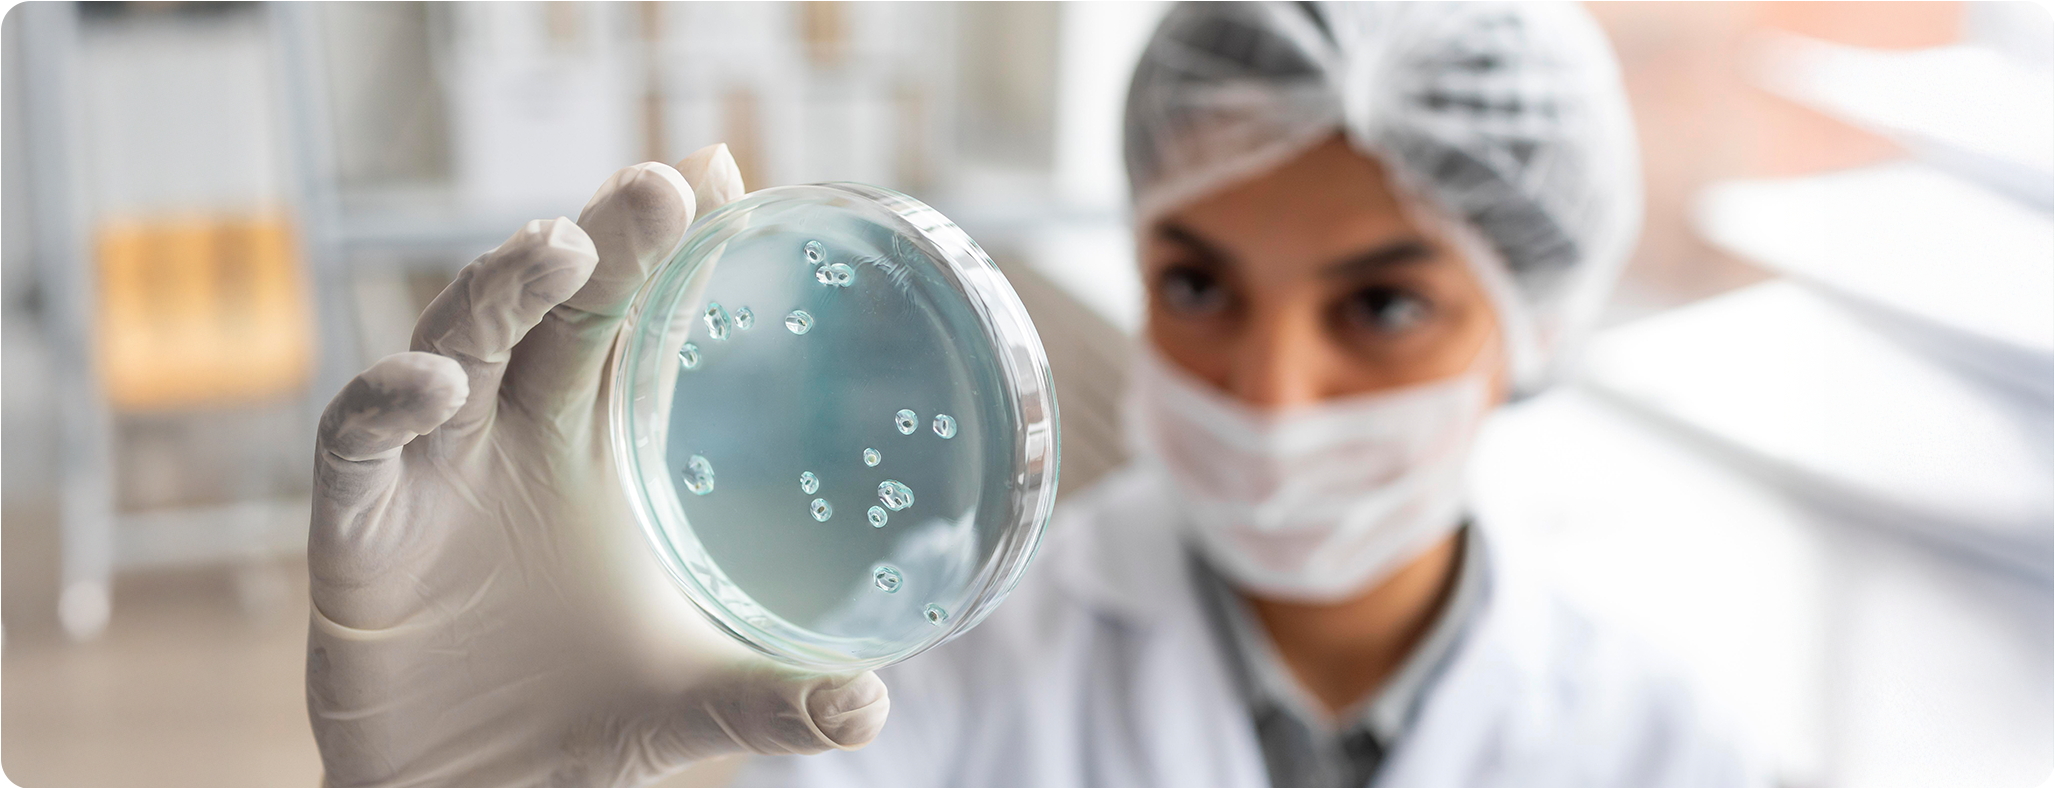
Blog_A2_

La medicina regenerativa representa una nueva frontera en la salud ya que además de tratar los síntomas, también busca reparar el daño desde el origen, activando los mecanismos naturales del cuerpo para regenerar tejidos y órganos.
A través de células madre y otros biológicos y sus factores de crecimiento, citocinas, interleucinas y exosomas, la medicina regenerativa aprovecha el lenguaje biológico con el que las células se comunican para restaurar equilibrio y funcionalidad.
Citocinas e Interleucinas: el lenguaje del sistema inmunológico
Las citocinas son proteínas que las células usan para comunicarse y coordinar defensas. Algunas son proinflamatorias (como TNF-α o IL-6), otras son antiinflamatorias (como IL-10 o IL-4).
Las interleucinas son una subfamilia que regula directamente la respuesta inmune: activan, frenan o dirigen las defensas según sea necesario.
En medicina regenerativa, modular estas moléculas permite reducir la inflamación crónica y estimular la reparación celular.
Células madre: fábricas naturales de regeneración
Las células madre son el pilar de la medicina regenerativa. Pueden autorrenovarse, transformarse en distintos tipos celulares y, sobre todo, secretar sustancias que reeducan el entorno dañado.
A través de su “secretoma”, liberan factores que calman la inflamación, inducen formación de vasos sanguíneos y activan células del propio tejido para regenerarse.
Este proceso —conocido como señalización parácrina— explica por qué terapias con células madre pueden mejorar desde lesiones articulares hasta enfermedades autoinmunes.
Factores de transferencia: educación inmunológica
Los factores de transferencia son pequeños péptidos derivados de leucocitos capaces de transferir memoria inmunológica de un individuo a otro.
Funcionan como “instrucciones moleculares” que enseñan al sistema inmunitario a responder equilibradamente: potenciando defensas cuando es necesario y evitando reacciones autoinmunes.
Por ello, se exploran como herramientas para reforzar la inmunidad y controlar inflamaciones persistentes.
Exosomas: mensajeros de la reparación
Los exosomas son diminutas vesículas que transportan mensajes biológicos entre células. Contienen ARN, proteínas y factores de crecimiento, actuando como correos celulares.
Pueden modular la inmunidad, estimular angiogénesis y acelerar la curación de tejidos, incluso sin usar células vivas.
En terapias regenerativas, los exosomas derivados de placenta o células madre reproducen muchos de los beneficios de las células originales y en casos con mayor precisión, como cuando es necesario pasar la barrera hematoencefálica.
Amnion de Biounity: ejemplo de terapia regenerativa sistémica
El Amnion de Biounity es un producto biológico liofilizado obtenido de la membrana amniótica y el cordón umbilical humanos.
Aplicado de forma subdérmica, libera interleucinas antiinflamatorias (IL-10), factores de crecimiento (TGF-β, VEGF, EGF) y componentes de la matriz extracelular que favorecen la regeneración.
Sus efectos incluyen:
- Reducción sistémica de la inflamación
- Modulación del sistema inmune
- Regeneración tisular y rejuvenecimiento celular
Además, puede mejorar la vitalidad, el equilibrio hormonal (útil en menopausia o andropausia) y el bienestar general, al restaurar el eje inflamación–regeneración del cuerpo.
Una visión moderna del equilibrio biológico
La medicina regenerativa nos enseña que curar no siempre significa reemplazar, sino restaurar el equilibrio que la naturaleza diseñó para el cuerpo humano.
Amnion y las terapias biológicas modernas son ejemplos de cómo la ciencia y la biología pueden trabajar juntas para regenerar, modular y sanar desde dentro.